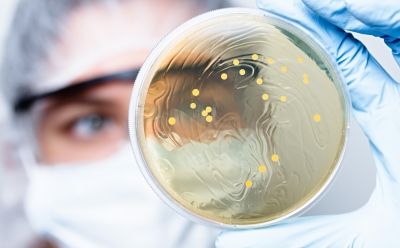
科学家正在观察培养皿中的细菌菌落

生物负荷和无菌控制策略
在制药或生物制药工艺中,生物负荷控制是确保患者用药微生物安全的关键。生物负荷控制或无菌过滤器是所有生物负荷控制策略必不可少的一环。通过环境监测、无菌测试和生物负荷测试,可确认工艺生物负荷控制情况。
推荐类别
生物负荷控制
相对于传统制药工艺,生物制药工艺存在更大的微生物污染风险,通常需要采取不同的控制策略。生产运营必须考虑生物负荷来源、不同的生物负荷控制选项以及整个工艺不同步骤的不同控制要求。借助可最大程度降低生物负荷污染风险的工艺设计,可减少流程相关的故障及由此造成的排查工作。
每一种生物负荷控制策略都依赖三个核心要素:
- 评估生产工艺不同步骤的生物负荷控制要求
- 确认工艺流程条件下的预期性能
- 监测工艺流程,确认在每次生产运行都能维持有效的生物负荷控制
生物负荷控制过滤器选择:生物负荷与无菌性的关系
过滤技术是所有生物负荷控制策略的关键一环。在整个制药和生物制药工艺过程中,可针对不用工艺环境因素选用不同类型的过滤器。例如,气体过滤器或空气过滤器可在环境与流体路径之间维持一道边界,可防止微生物进入工艺流体,最大限度降低潜在有害物质释放到环境中的风险。
为保障药物制成品的无菌性,需要让液体流经不同步骤中的多个生物负荷控制或灭菌过滤器。生物负荷控制或灭菌过滤器选择在很大程度依赖特定操作和工艺风险,因此需基于风险分析指导选择。关于工艺流体、过滤材料相容性以及生物负荷控制或无菌过滤的信息,均可作为过滤器选择参考依据。其他重要考虑因素包括,确认过滤器规格是否符合运行要求,以及是否满足特定工艺要求的形式和尺寸。
不同的过滤器形式方便灵活选择:
- 柱式过滤器常用于需要较大过滤面积和/或更低单位运行成本的大型工艺流程。这类过滤器搭配不锈钢外壳,可承受高温高压灭菌和多次在线蒸汽灭菌循环。
- 囊式过滤器是一次性独立式过滤器,省去了组装、清洁和验证不锈钢外壳的时间和成本。过滤囊可通过高压高温或伽马射线辐照灭菌,也可购买预灭菌产品。
与经验丰富的过滤产品伙伴合作,可以简化气体和通气型过滤器、生物负荷控制或无菌过滤器产品选择。
优化过滤器性能
缩小生物负荷控制或无菌过滤器选择范围后,下一步就是优化过滤器或过滤器组性能,最大限度提升过滤效率。预过滤器是一种颇具成本效益的选择,可减少工艺流体颗粒物水平;在无菌过滤器成本较为昂贵时,常借用预过滤器提升无菌过滤器过滤容量。妥善选择的预过滤器可提供所需的产品质量,并提高整体工艺流程的经济性。
过滤器选择和过滤器组优化的一环是妥善选择过滤器尺寸,或针对工艺流体开展Vmax™研究。基于这类小规模研究的结果,可预估大规模生产工艺所需的过滤面积。
确认过滤器性能
选定过滤器后,监管指南要求制药和生物制药产品生产商必须证明其过滤器适用。具体要求取决于宣称的微生物去除水平:针对关键工艺步骤,生物负荷控制过滤器的要求与无菌过滤器不同。监管指南概述了证明过滤器适用性及验证性能的要求。
在每次生产运行过程中,必须验证过滤器性能。完整性测试是确认过滤器是否符合预期微生物截留水平的简单方法。针对宣称无菌的产品,全球各地的监管机构都要求在使用前后针对其无菌过滤器进行完整性测试以验证滤器性能。
因此,成功通过完整性测试是过滤器验证和生产运行之间的过渡纽带。随着制药和生物制药工艺流程系统的发展,越来越多的监管重点落在了完整性测试、系统设计以及完整性测试执行时机上。了解过滤系统设计可参考的要求和相关风险。
相关文章
- 本应用说明描述了Cellvento® 4CHO-X细胞扩增培养基的优势和性能,这款培养基专门开发用于从细胞复苏到N-1阶段的多个细胞扩增步骤,以生成更多生物质接种分批补料生产生物反应器。
- 快速单克隆抗体开发计划可以在开始转染的9个月后交付GMP原料药。我们的mAbExpress™计划具有快速交付、高性价比等优势,非常适合您项目的早期临床研究并全程提供监管支持。
- Multivariate data analysis (MVDA) makes possible a proactive, real-time approach to monitoring, controlling, and predicting quality and productivity in biomanufacturing. The use of proven software with guided PCA and PLS model creation means you don’t need to be a data scientist to explore and analyze your data.
- Key aspects of single-use assembly qualification including quality by design (QbD), quality risk management (QRM) and operator handling and training.
- Streamline upstream process monitoring with embedded Raman ready-to-use models for easy implementation and improved process understanding
- 查看完整内容 (21)
相关实验方案
- This article describes a purification process resulting in low nanoparticulate impurities sucrose, enabling more stable protein formulations.
- 查看完整内容 (1)
查找更多文章和实验方案
相关网络研讨会
本次网络研讨将就设计验证多批次或延长工艺时间的过滤器使用情况,提供有关设计方法方面的建议。
该网络研讨会将比较现版与拟议的更改,并重点介绍在EMA国家、PICS 成员国和WHO合规国家生产,或出口到这些国家的公司特别感兴趣的领域。
本次网络研讨会介绍了一种过滤模型和测试方法,旨在快速有效地设计更佳的双重过滤工艺。
相关资源
- Brochure: Mission: Control - Strategies for Effective Bioburden and Aseptic Control
This brochure discusses Radiello® Passive Samplers and their application in vapor intrusion assessments.
- Article: A Holistic Approach to Bioburden Control in Downstream Processing
This article highlights the need for effective strategies to monitor and control microbial contamination in bioprocessing environments.
- Article: Validation and Qualification of Sterile Filters for INDs
The manufacture of investigational medicinal products presents additional challenges and complexity in comparison to commercially manufactured and marketed products.
- Brochure: Vmax™ Constant Pressure Test for Reliable Filter Sizing
This document describes how to perform a small-scale normal flow filtration study with Vmax™ filter sizing method to assess the performance of any feed solution on a membrane filter.
我们可以提供哪些帮助
如有任何疑问,请提交客户支持请求
或联系我们的客户服务团队:
发送电子邮件至 custserv@sial.com
或致电 +1 (800) 244-1173
更多支持
- Chromatogram Search
Use the Chromatogram Search to identify unknown compounds in your sample.
- 计算器与应用_缓冲液计算器_HPLC方法转换计算器-默克生命科学
默克该工具箱包括用于化学、生命科学、材料科学等方面的科学研究工具和资源。
- Customer Support Request
Customer support including help with orders, products, accounts, and website technical issues.
- FAQ
Explore our Frequently Asked Questions for answers to commonly asked questions about our products and services.
如要继续阅读,请登录或创建帐户。
暂无帐户?




